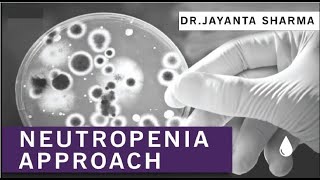

Shared 5 years ago
210K views
Shared 5 years ago
78K views
Shared 4 years ago
3.4K views
Shared 1 year ago
1.6K views
Chronic neutropenia is a condition characterized by a consistently low number of neutrophils, a type
Shared 4 months ago
1.1K views
Shared 11 months ago
2.4K views
Shared 9 months ago
35 views
Shared 5 days ago
150 views
Shared 7 months ago
122 views
Shared 10 months ago
1.7K views
Shared 8 months ago
77 views
Shared 1 year ago
135 views
Shared 8 months ago
136 views
Shared 9 months ago
107 views
Shared 11 months ago
259 views
Shared 3 years ago
1K views
Shared 8 months ago
736 views
Shared 9 months ago
447 views
Shared 1 year ago
160 views
Shared 5 months ago
5 views
Shared 1 year ago
982 views
Shared 2 years ago
135 views
Shared 5 months ago
5 views
Shared 5 months ago
6 views